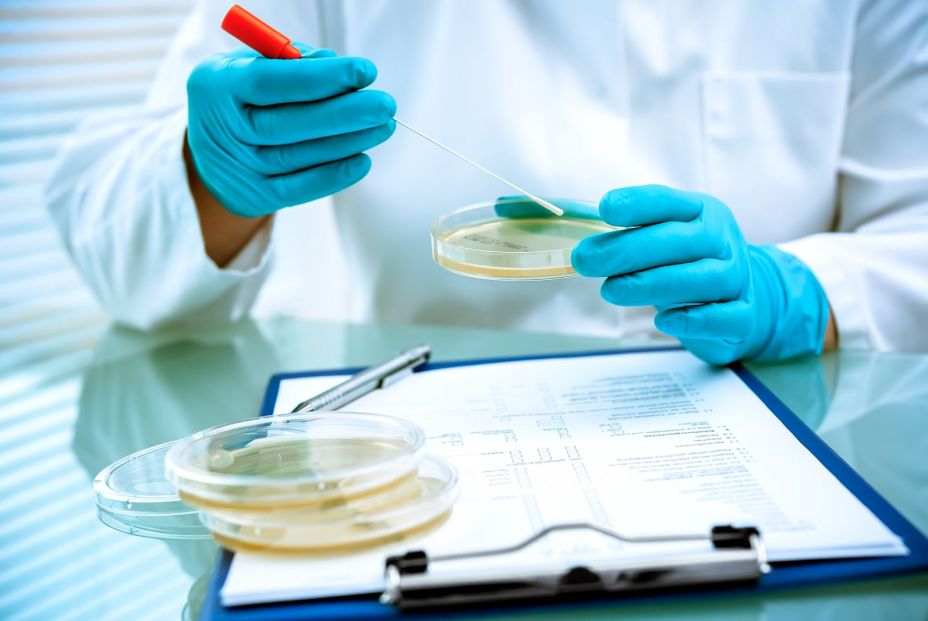
Foto: Bigstock. Foto: Bigstock.

Utilizando una tecnología de edición genética llamada CRISPR para aumentar la eficiencia de producción de un hongo, científicos de la Universidad de Jiangnan, en China, han logrado reducir su impacto ambiental hasta en un 61%, todo ello sin añadir ADN extraño.
El hongo modificado genéticamente tiene sabor a carne y es más fácil de digerir que su contraparte natural. El trabajo se publica en la revista Trends in Biotechnology de Cell Press.
"Existe una demanda popular de proteínas mejores y más sostenibles para la alimentación", recuerda Xiao Liu, autor principal del estudio e investigador de la Universidad de Jiangnan. "Logramos que un hongo no solo fuera más nutritivo, sino también más respetuoso con el medio ambiente, mediante la modificación de sus genes".
La ganadería es responsable de aproximadamente el 14% de las emisiones globales de gases de efecto invernadero. La cría de ganado también ocupa tierras y requiere grandes cantidades de agua dulce, recurso que ya se encuentra en riesgo debido al cambio climático y la actividad humana. Las proteínas microbianas, incluidas las presentes en levaduras y hongos, se han consolidado como una alternativa más sostenible a la carne.
Entre las opciones exploradas hasta ahora para la obtención de micoproteínas, u hongos con contenido proteico, el hongo Fusarium venenatum destaca por su textura y sabor naturales, muy similares a los de la carne. Su uso alimentario está aprobado en numerosos países, como el Reino Unido, China y Estados Unidos.
Sin embargo, Fusarium venenatum posee paredes celulares gruesas que dificultan la digestión de sus nutrientes por parte de los humanos. Además, su cultivo requiere muchos recursos; incluso la producción de pequeñas cantidades de micoproteína exige un gran aporte de estos. Las esporas se cultivan en enormes tanques metálicos llenos de un sustrato compuesto de azúcar y nutrientes como el sulfato de amonio.
Liu y su equipo se propusieron explorar el potencial de aumentar la digestibilidad y la eficiencia de producción de Fusarium venenatum utilizando CRISPR, sin introducir ADN extraño en los genes del hongo.
Para ello, eliminaron dos genes asociados a las enzimas quitina sintasa y piruvato descarboxilasa. La eliminación de la quitina sintasa redujo el grosor de la pared celular del hongo, permitiendo que una mayor cantidad de proteína intracelular estuviera disponible para la digestión. La eliminación del gen de la piruvato descarboxilasa contribuyó a optimizar el metabolismo del hongo, de modo que requiriera menos nutrientes para producir proteínas.
Los análisis demostraron que la nueva cepa de hongo, denominada FCPD, requería un 44% menos de azúcar para producir la misma cantidad de proteína en comparación con la cepa original y lo hacía un 88% más rápido.
"Mucha gente pensaba que cultivar micoproteína era más sostenible, pero nadie había considerado realmente cómo reducir el impacto ambiental de todo el proceso de producción, especialmente en comparación con otros productos proteicos alternativos", advierte el primer autor, Xiaohui Wu, de la Universidad de Jiangnan.
Posteriormente, los investigadores calcularon la huella ambiental del FCPD, desde las esporas en el laboratorio hasta los productos cárnicos inactivados, a escala industrial. Simularon la producción de FCPD en seis países con diferentes estructuras energéticas -entre ellos Finlandia, que utiliza principalmente energías renovables, y China, que depende más del carbón- y descubrieron que el FCPD tenía un menor impacto ambiental que la producción tradicional de Fusarium venenatum, independientemente de la ubicación. En general, la producción de FCPD generó hasta un 60% menos de emisiones de gases de efecto invernadero durante todo su ciclo de vida.
El equipo también investigó el impacto de la producción de FCPD en comparación con los recursos necesarios para producir proteína animal. En comparación con la producción de pollo en China, descubrieron que la mioproteína de FCPD requiere un 70% menos de tierra y reduce el riesgo de contaminación del agua dulce en un 78%. De esta forma el informe concluye que los alimentos editados genéticamente como este pueden satisfacer la creciente demanda de alimentos sin los costos ambientales de la agricultura convencional".



